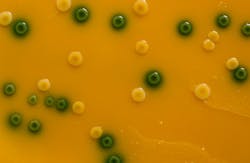
villorejo/iStockphoto/Thinkstock villorejo/iStockphoto/Thinkstock

A Listeria outbreak, most likely linked with "Hispanic-style" cheese, has killed one person in California and has sickened seven people in Maryland, the Associated Press reported this week, quoting sources from the U.S. Centers for Disease Control and Prevention (CDC).
The cheese has been traced to a Delaware-based company, Roos Foods, which started a recall of 16 varieties of cheese, including its Mexicana, Amigo, Anita and Santa Rosa De Lima brands. The products were distributed in Maryland, Virginia and the Washington, D.C.
RELATED: Diseases linked to Salmonella, Campylobacter decrease in Europe
The CDC also stated that three of the people affected were newborns but it did not specify whether the deceased victim was one of them. It has been established that all of those sickened in Maryland had consumed either soft or semi-soft cheese produced by Roos Foods and sold at different locations of a grocery store chain. Patients were diagnosed with Listeria infection between August and November 2013, reports said.
Infections caused by Listeria bacteria are among the most common foodborne diseases, most often stemming from eating food contaminated with the bacterium Listeria monocytogenes. Commonly reported symptoms include muscle pain, fever, diarrhea and gastroenteritis. The disease can also affect the central nervous system through the bloodstream. It poses a particular risk to pregnant women because it can pass through to the baby and cause serious damage.